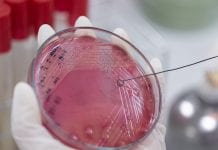

One Health Related News
Fighting the AMR paradoxes in the age of COVID-19
Mariano Votta, Director of the Active Citizenship Network/Cittadinanzattiva, and Neda Milevska-Kostova, Vice Chair of the International Alliance of Patients Organisations, discuss the threat of...
Global leaders advocate urgent action on antimicrobial resistance
As the antimicrobial resistance crisis accelerates across the globe, world leaders are advocating for urgent action to combat the problem.
The leaders, including the heads...
Could COVID-19 mink spread lessen the effectiveness of a vaccine?
The European Centre for Disease Prevention and Control (ECDC), an agency of the European Union, has warned that the spread of COVID-19 from minks...
What do you know about the One Health concept?
One Health is a concept that recognises interlinks between human health, animal health and the environment, and now it’s time for a more aligned...
60% human diseases originate in animals: Could One Health tackle this?
The One Health approach unites human, animal, food and environment professionals to tackle human diseases and fight antimicrobial resistance.
It is discovered that many of...
Assessing the environmental risk of pharmaceuticals
AstraZeneca’s Jason Snape, outlined his company’s approach to the environmental risk assessment of human medicinal products and what more needs to be in place...
HCWH Europe calls on MEPs to push for greater action on antimicrobial resistance
Health Care Without Harm (HCWH) Europe has written to MEPs to urge them to put pressure on the European Commission to scale up efforts...
The Safer Pharma campaign to eliminate pharmaceuticals in the environment
Adela Maghear outlines the dangers of pharmaceuticals in the environment and the measures needed to reduce their threat to human and environmental health.
Pharmaceutical pollution...
Working with One Health – learning from equine tendon disease
Professor Roger KW Smith, of the Royal Veterinary College, provides a valuable insight into how research in equine tendon disease is paving the way...
Animal health for the benefit of all
Roxane Feller, the secretary general of AnimalhealthEurope, provides an overview of the important role of the animal health industry in animal welfare, food safety,...